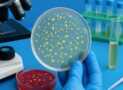
Master Bacteriology :Hands-On Lab Skills for Beginners

[Free] Data Types And Methods Of Data Collection In Research
Research Methodology – Free Course
What you’ll learn
- Students will get knowledge of data it’s importance in research.
- They will come to know types of data, methods of data collection with suitable examples.
Requirements
- None
Description
After completing the course students will be able to get importance of data in research, types of data, sources of data with suitable examples. Researchers can get methods of data collection. Researchers will come to know the parameters for selection of data collection methods. Researchers will be able to select the data collection method for their research.
Author(s): Shailaja Patil